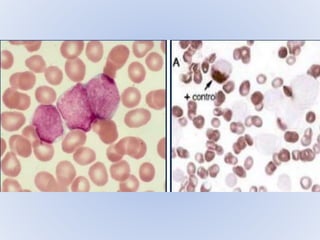
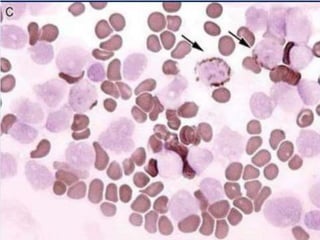

Acute myeloid leukemia (AML) is a type of acute leukemia characterized by the rapid growth of abnormal white blood cells that build up in the bone marrow and blood. The document discusses the pathophysiology, signs and symptoms, laboratory findings, and classifications of AML according to the French-American-British (FAB) and World Health Organization (WHO) systems. It defines eight subtypes of AML under the FAB classification based on morphological criteria and immunophenotyping.